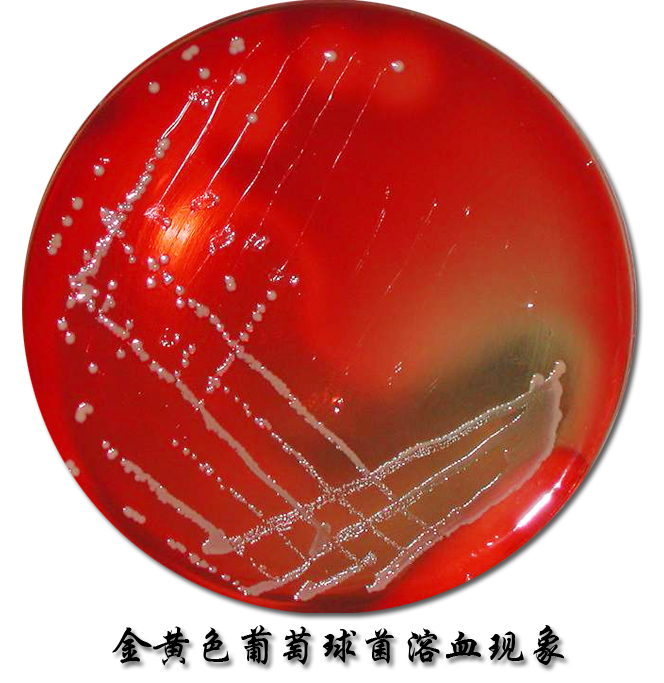

《兽医微生物学》是动物医学专业的必修的专业基础课,通过本课程的学习使学生较为全面地认识微生物及其在自然界中的作用,掌握动物微生物学的基本概念和理论,畜禽常见传染病,人畜共患传染病病原的基本特征及微生物学诊断技术,为动物医学专业学生掌握预防兽医学的基本知识和技能打下坚实基础,利用微生物学与免疫学的知识和技能来诊断和防治动物传染病和人畜共患传染病,保障畜牧业健康发展,同时避免畜产品危害人类的健康,因此,课堂上对微生物学的一些基本概念、基本理论和基础知识比较系统和详细的阐述。

.jpg)
.jpg)

课程资料:




![]() |
||||||||||||
首页 |
||||||||||||
|
||||||||||||
|
||||||||||||